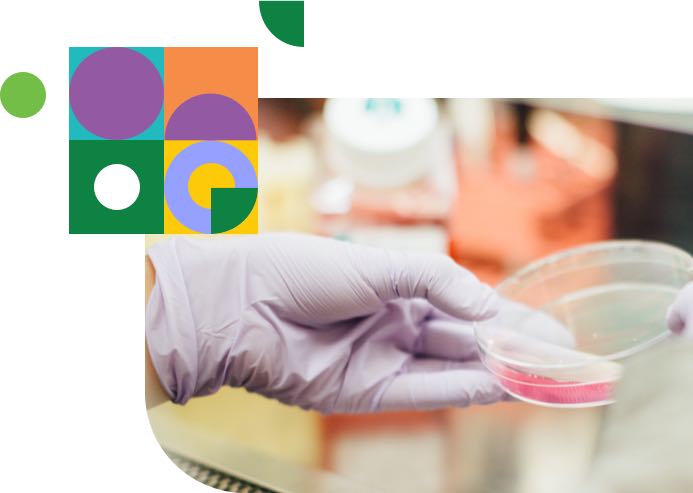
Imagen sobre el laboratorio de Modern Research

Desarrollamos e investigamos, de la mano de un equipo de expertos, fórmulas innovadoras acordes a las necesidades de nuestros clientes.




Estamos certificados y registrados de acuerdo a la normatividad vigente ante Cofepris, Secretaria de Salud y recientemente hemos obtenido el reconocimiento en HACCP (Hazard Analysis and Critical Control Points)
Maquila de productos
En Modern Research nuestro principal objetivo es brindar salud y bienestar a las familias de México.
Somos un laboratorio líder en la producción de suplementos alimenticios de alta calidad. La innovación y tecnología avanzada nos permite elaborar productos 100% de origen natural y de la más alta calidad, para el cuidado de la salud.

Desde la elaboración de las formulas, hasta la venta en piso, nuestros clientes hablan por nuestro trabajo.
Conocer más


Dirección: Industria Zapatera 153, Fracc Industrial Zapopan norte, CP 45130 Zapopan, Jalisco.